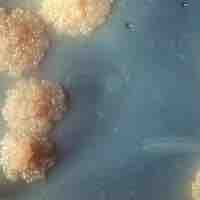
Thumbnail

Chapter 14
Pathogenicity
By Boundless

Microbes gain access to human tissues via mucosal surfaces within the body or epithelial surfaces on the outside of the body.
Infection begins when an organism successfully colonizes a host by entering the host's body, growing and multiplying from there.
Pathogenicity islands (PAIs) are a distinct class of genomic islands acquired by microorganisms through horizontal gene transfer.

Adhesins are cell-surface components or appendages of bacteria that facilitate bacterial adhesion to other cells or to inanimate surfaces.

Individuals who are weak, sick, malnourished, have cancer, or are diabetic have increased susceptibility to chronic or persistent infections.
Several barriers protect organisms from infection including mechanical, chemical, and biological barriers.

Normal microbiota are the microorganisms that reside in the bodies of all humans.

Opportunistic microorganisms lay dormant until the hosts' immune system is suppressed and then they seize the opportunity to attack.

Cooperative behavior, includes mutualism and altruism, benefits one party while the other performs a certain behavior.

Although humans host many beneficial bacteria, certain pathogens can penetrate host defenses and cause illness or disease.

Attachment of bacteria to host surfaces often aided by pili or fimbrae is required for colonization during infection or to initiate formation of a biofilm.

Biofilms will form on virtually every non-shedding surface in a non-sterile aqueous (or very humid) environment.

Microorganisms produce poisonous substances called toxins.

Direct damage to the host is a general mechanism utilized by pathogenic organisms to ensure infection and destruction of the host cell.

Type III and IV secretion systems are utilized by pathogenic bacteria to transfer molecules from the bacterial cell to the host cell.

Both plasmids and lysogeny are used by bacteria and viruses to ensure transfer of genes and nucleic acids for viral reproduction.
Siderophores produce specific proteins and some siderophores form soluble iron complexes to aid in iron acquisition for survival.

A pathogen or infectious agent is a microorganism such as a virus, bacterium, prion, or fungus that causes disease in its host.

A pathogen's success depends on its ability to evade the host's immune responses.
Virulence regulation is a combination of the specific traits of the pathogen and the evolutionary pressures that lead to virulent traits.

Pathogens must have a way to be transmitted from one host to another to ensure their species' survival.

A fungus is a member of a large group of eukaryotic organisms that includes microorganisms that exhibit pathogenicity.

Protozoa are a diverse group of unicellular eukaryotic organisms, many of which can cause disease.

Parasitic worms, often referred to as helminths, are a division of eukaryotic parasites.

Algae can act as pathogens like any other microbe.